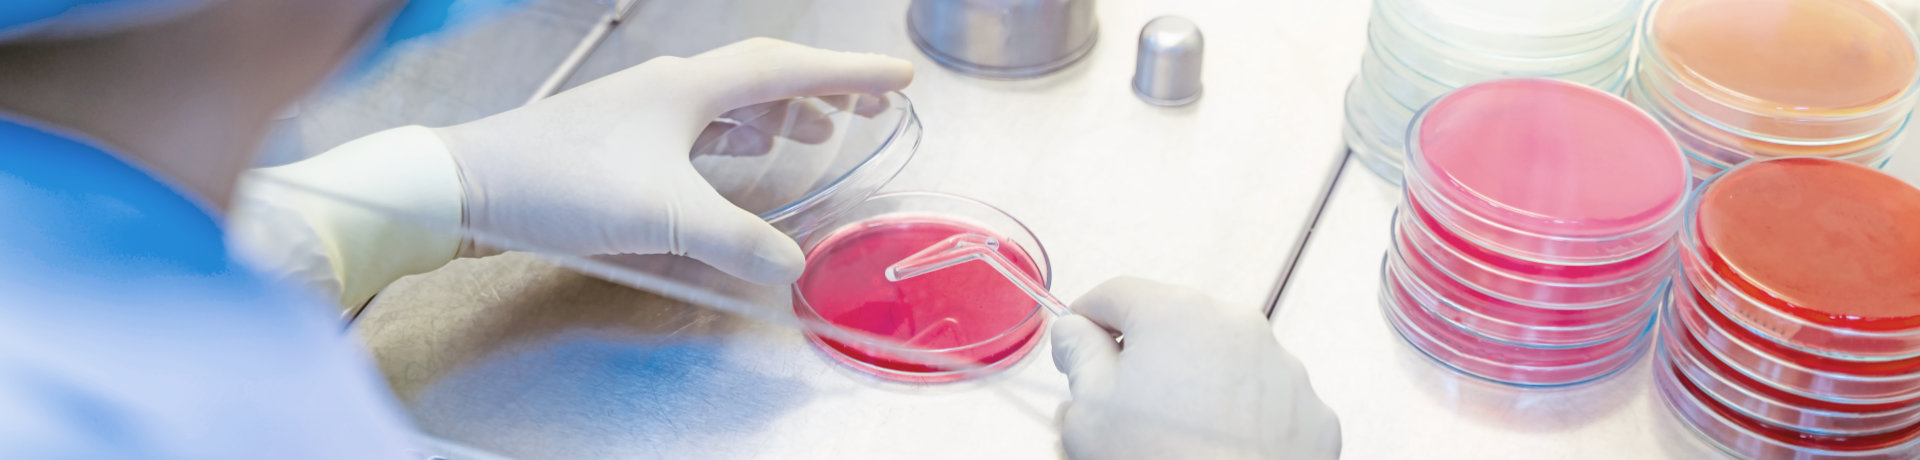

セルプロセッシングセンターにおける製造ライセンスに準拠します。医療に使用される細胞として、細胞の安全性、生存率、分化制御の安定性を確保するために、操作手順に従い、原材料、培養、さまざまなテスト、および凍結保存などを厳密に行います。
幹細胞、免疫療法、炎症免疫療法
臨床研究のコンセプト
日本、台湾、ドイツの医療チームは、特許を取得した細胞技術を開発し、主要医療機関と提携していき、臨床研究および抗炎症製品の開発に取り組んでいます。
研究プロセス

検体の組織の確認

栽培したものを厳選

栽培のテスト

保存と管理

再生医療センター
細胞培養クリーンルームのオペレーターは、日本の医療およびバイオテクノロジーの専門家(博士)が、細胞培養の知識と5年以上の臨床診療の経験を有している必要があります。一方の品質管理では、再生医療製品に求められる最高の品質管理項目である「安全管理」、「製造環境」、「人事管理」などを求められているGMPとQMSの試験基準を同時に実施しています。
分析機器-品質と安全性の検査



-
ドナースクリーニング
-
検体テスト項目
-
安全性と毒性の検査及びテスト
-
製造工学管理
-
栽培と及び設備管理
-
パフォーマンスチェック
-
保存管理システム

品質管理と品質証明
当社は、GMP(厚生労働省規則、グッドマニュファクチャリングプラクティスによって規定された品質基準)の基準に従い、ソフトおよびハード基準を満たすすべての施設を採用し、法規制を守りながら、細胞製造研究を運営および管理しています。
-
空調・電気機械管理室
-
製品プロセス監視室
-
中央監視室
-
研究室
-
製品完成試験室
-
更衣室
-
オートクレーブルーム
-
資材保管室
-
製品保管室
-
細胞培養室
-
オペレーター専用の出入り部屋
-
原材料(検体)試験室
| 名稱 | 細胞数 | 増殖細胞数 | 栽培の面積 | 初代培養の細胞数 |
|---|---|---|---|---|
| BIRE-AD | 1X105(100万) | 4X106(400万) | 4X106(400万) | 5.6X108(5.6億) |
| BIRE-UC | 2X105(200万) | 8X106(800万) | 4X106(400万) | 2X109(20億) |
CPCトレーニングルーム
CPC(細胞プロセッシングセンター)は、米国連邦標準Fed.Std.209D(目標粒子サイズ0.5μm)を採用し、医薬品グレードと同等の基準で加工・培養を行うハイレベルな細胞培養センターで研究を行っています。
クラス10,000のクリーンルーム
クラス1,000の細胞処理室
クラス100の生物学的安全キャビネット
*米国連邦標準Fed.Std.209D(ターゲット粒子サイズ0.5μm)
当社の目標として、病院や医療研究機構向けの細胞療法の研究および製造サービスを行うことと、迅速な対応が求められる臨床検査のニーズに対して柔軟かつフレンドリーなサービスを提供することです。
